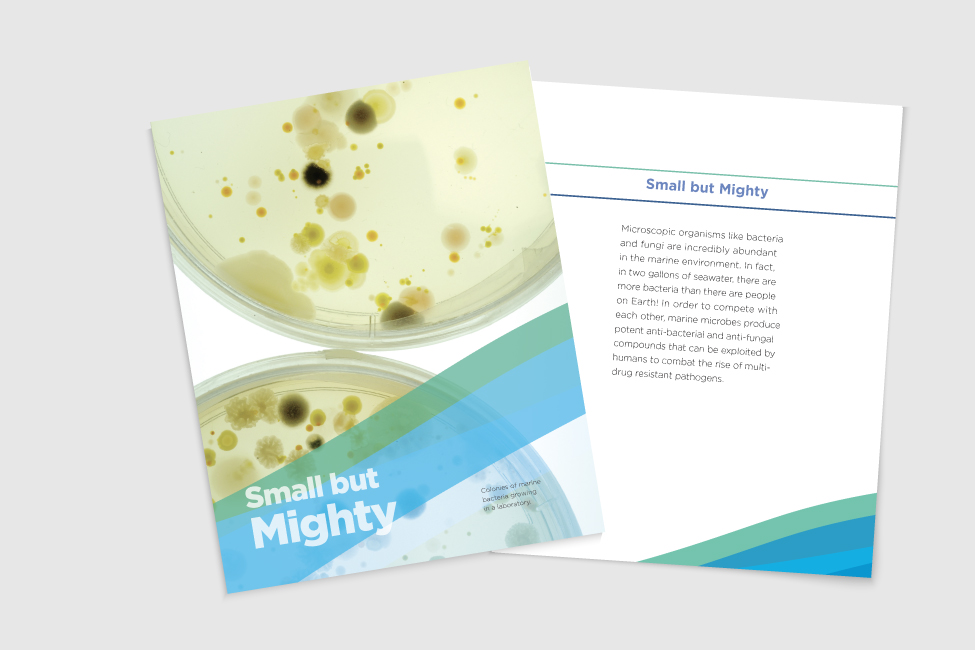
image 6

50 Years of Ocean Science for a Better World® exhibit
50 Years of Ocean Science for a Better World® exhibit at the Elliot Museum
As part of FAU Harbor Branch Oceanographic Institute’s 50th Anniversary celebration, this historical exhibit was erected at the Elliot Museum in Stuart, FL. The displays give museum visitors a summary, through photos and text, of FAU Harbor Branch’s 50 years of solution-oriented research and current efforts in finding solutions to the pressing issues facing our fragile aquatic ecosystems.
GOALS: This exhibit is designed to raise community awareness of FAU Harbor Branch’s rich history and current research.
CLIENTS: FAU Harbor Branch Administration
DEPARTMENTS: FAU HBOI: Executive Team, Development, Education and Outreach